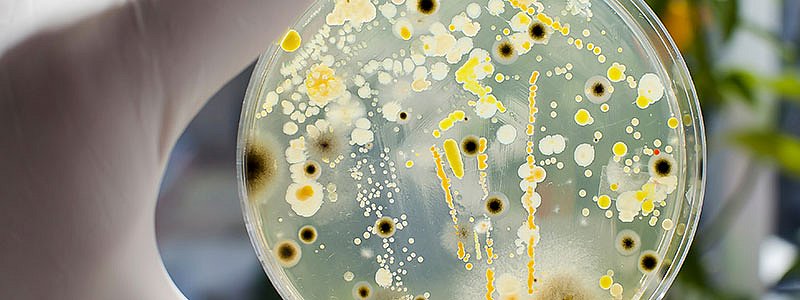

Lackieren
Lack als Beschichtungsstoff erfüllt vielfältige Aufgaben, etwa als Anwendung für dekorative Zwecke oder als Schutz. In der Industriellen Oberflächentechnik wird Lack am häufigsten gesprüht oder gespritzt. Auch andere Verfahren wie Tauchlackierung, Coil Coating oder Elektrostatische Spritzverfahren kommen zum Einsatz.
Anzeige
Sind Sie ein Unternehmen, eine PR-Agentur oder ein Fachautor und möchten Ihre Fachbeiträge auf Oberfläche-Online veröffentlichen? Nehmen Sie einfach per Mail oder telefonisch Kontakt mit uns auf!